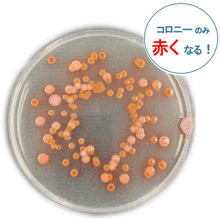
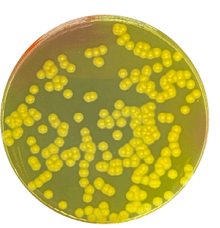
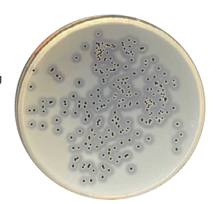

食品微生物検査用の低額装置・
消耗品類をまとめてご紹介します!!

弊社取り扱いの食品微生物検査用の低額装置や消耗品類をまとめてご紹介します。
お手頃価格で導入しやすい装置・消耗品類です。デモ機貸し出しや、サンプルのご提供も可能ですので是非ご検討ください。
【こんな方にオススメ】
・微生物検査業務を行っている方
・これから微生物検査を行う予定の方
・食品製造・医薬品製造で衛生管理に従事している方


◇ATPルミノメーター 「EnSURE™Touch」


一台二役の拭き取り検査装置
▶ATP拭き取り検査
表面の拭き取り検査に。10秒で結果
▶衛生指標菌 菌数検査
表面拭き取り or 食品サンプルを
所定時間培養後10秒~10分で結果
・一般生菌:7時間
・大腸菌・大腸菌群:6時間
◇インキュベーター・ワークステーション除染システム「マイコフォグ」

微生物検査の消耗品類
消耗品類は無料サンプルをご提供しています!
◇滅菌済みホモジナイズバッグ「ストマフィルターシリーズ」
◇滅菌済みホモジナイズバッグ「バッグフィルターシリーズ」
◇滅菌済みリン酸緩衝生理食塩水「ステリウォーター」
◇生培地「CSC培地シリーズ:標準寒天培地」
◇生培地「CSC培地シリーズ:卵黄加マンニット食塩寒天培地」
◇生培地「CSC培地シリーズ:ベアードパーカー寒天培地」
◇食中毒菌検出/残留物質検出 拭き取りキット「InSiteシリーズ」

ディバイス不要の拭き取りキット
▶リステリア:
黄色から黒色へ変色で推定陽性
▶サルモネラ:
紫色から黄色へ変色で推定陽性
▶残留物質検出:残留タンパク
残留グルテン
残留ブドウ糖・乳糖

全て100万円以下!
初めての導入にオススメの装置
◇パドル式ホモジナイザー「マスティケーターシリーズ」
◇自動秤量希釈・定量分注装置「スマートダイリューター」
◇マニュアル式コロニーカウンター「スキャン50シリーズ」
◇電気抵抗式水分活性測定装置「AW-View」
◇エアサンプラー「スピンエアー・シリーズ」
- オンラインセミナー情報 -
微生物検査を行っている方に役立つ情報をお届け!!

『詳しく解説!セントラル科学貿易の微生物迅速検査装置』
原理が異なる微生物迅速検査装置について、それぞれどのような原理で測定するのか詳しく解説し、各装置が得意とする分野や導入事例をご紹介します。
<紹介する製品>
クオリバックス:PCRによる病原性細菌のスクリーニングシステム
イノベート:微生物のATPを発光させ微生物汚染をスクリーニング
エンシュアタッチ:拭き取りキットでの衛生指標菌の定量検査
「微生物迅速検査装置」セミナー見逃し配信の申込はこちらから

『AI機能搭載モデルも!次世代コロニーカウンターのご紹介』
次世代コロニーカウンター3機種をご紹介します。
特に注目のAI機能搭載モデルはこれまで測定できなかったシャーレの縁に生育したコロニーや、カビまで正確に測定できるようになりました。実機を用いて解説します。
<紹介する製品>
スフィアフラッシュ AI:AI搭載で、高精度の測定を実現
スキャンステーション:培養しながら全自動カウント
オートコル:培養済みシャーレを全自動カウント
「次世代コロニーカウンター」セミナー見逃し配信の申込はこちらから
セントラル科学貿易の数ある製品の中から、選りすぐりの製品をご紹介した
カタログ「製品ピックアップガイド」の2024-25年版(最新版)をこちらからダウンロードいただけます。

微生物検査の品質・効率でお困りではありませんか?
弊社取り扱いの微生物検査省力化機器を紹介した動画はこちらからご視聴いただけます。
資料請求/お問合せ
フォームが表示されるまでしばらくお待ち下さい。
恐れ入りますが、しばらくお待ちいただいてもフォームが表示されない場合は、こちらまでお問い合わせください。